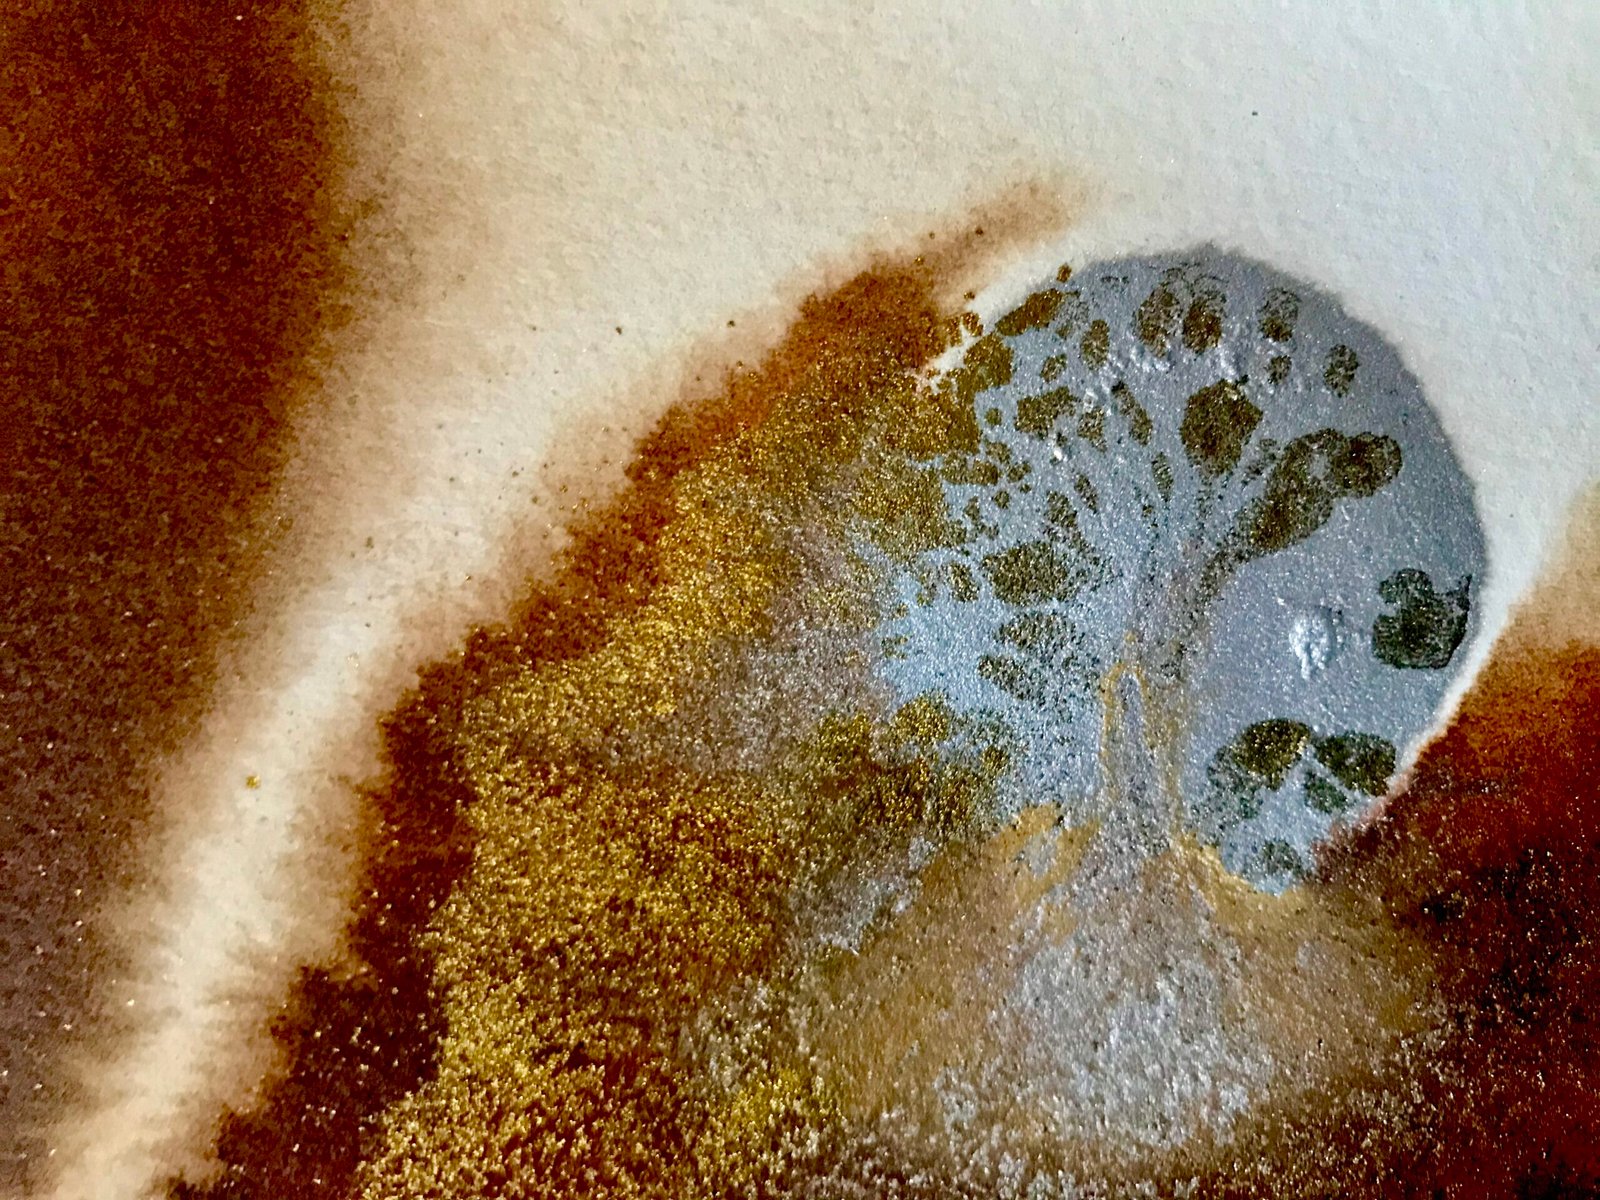

In my last two or three exhibitions, I have been showing ink-based reliefs. The idea here was to show two pieces of paper joined to become one shape, based around the idea of partnership or couples of one kind of another. I sprayed two pieces of paper with water, before pouring different coloured acrylic inks over the surfaces. In some areas the inks would merge, whilst others they would avoid each other, but always resulting in interesting patterns and tones.